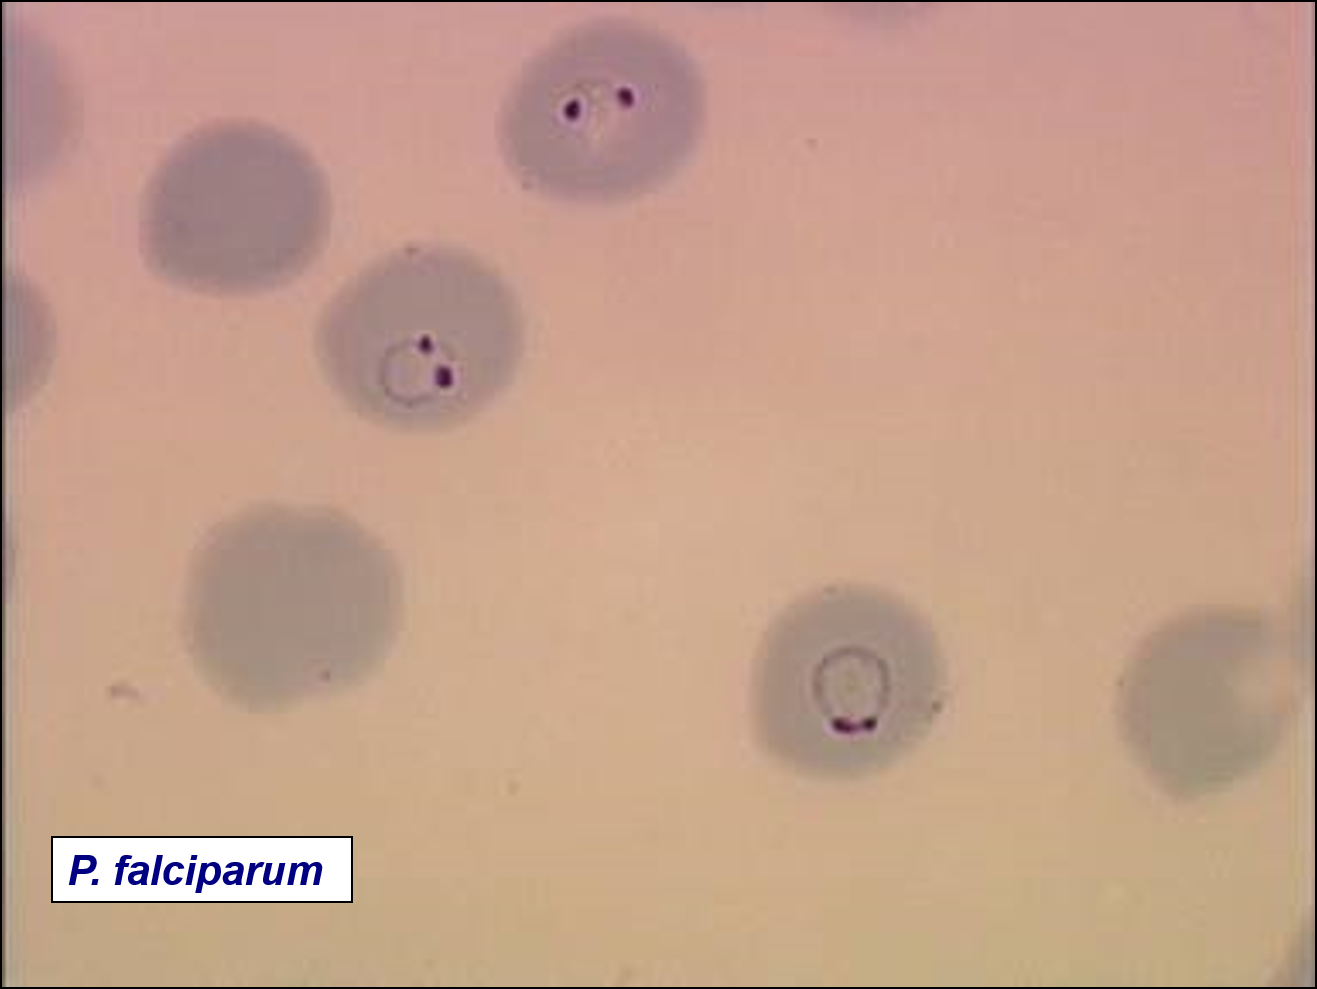

what is the most common cause of fever in a returned traveler?
malaria
how do many docs misdiagnose malaria?
forget to get a travel history!
mosquitoes carry malaria- where do they store it?
salivary gland
vector for malaria?
anopheles mosquito
non human reservoir for malaria?
none except for macaques with P. knowlesi
“hidden plasmodia” dilemma
after infection, the sporozoites circulated free for only about half an hour, and then vanished for several days they hide/go to liver cells!!!
sporozoites
come from mosquito
tiny thread like
short lived in the blood –> travel to the hepatocytes

schizont
in liver
asymptomatic
contains merozoites (the merozoites are infective for RBCs)
merozoites
how many in Pv? Pf?
merozoites are infective daughter cells that invade RBCs
10,000 in Pv
30,000 in Pf
what form is transmitted by mosquito saliva?
sporozoites
after merozoites infect the RBCs, what do they form?
ring-stage trophozoites
ring stage trophozoites turn into …
which do what?
schizonts
schizonts rupture and release merozoites which infect more RBCs
hypnozoite
- Dormant liver stage in P. vivax and P. ovale -> can have recurrent infxns
- Release blood stage parasites weeks to months after primary infection

which two malaria types can have recurrent infections due to a dormant stage?
P vivax and P ovale

1 - mosquito bites and injects sporozoites
2 - sporozoites go to liver and form schizonts which rupture and release merozoites (exo-erythrocytc cycle)
3 - merozoites go to blood and for primary ringed trophozoites
–they can either become gametocyte or mature trohpzoite
4 - mature trophozoite becomes schizont which ruptures and releases more merozoites into blood (erythrocytic cycle)
5 - gametocytes form new gametocytes which can infect new mosquito if an uninfected mosquito bites person
6) sporogenic cycle = gametocytes inside new mosquito create macrogametocyte and then an oocyst which creates new sporozoites
how long does it take for malaria symptoms to appear?
P falciparum
P ovale
P vivax
P malariae
Pf 8-11 days
Po/Pv 10-17
Pm 18-40
onset of symptoms of malaria coincides with….
the start of the erythrocytic cycle
incubation with ______can be up to 20 years due to chronic subclinical erythrocytic stage
P. malariae
3 evolutionary defenses against malaria
Duffy antigen negative (P viva uses duffy agent to enter RBCs)
sickle cell trait (selective sickling of falciparum infected RBCs)
G6PD deficiency (malaria parasites grow poorly in G6PD deficient rbcs d/t increased ROS in rbcs)
classic triad of symptoms for malaria
fever, chills, headache
three clinical types of malaria
acute uncomplicated
severe malaria
hyperreactive malarial syndrome (tropical splenomegaly)
uncomplicated (mild) malaria
Occurs with all Plasmodium species
—–sudden episodes of: fevers, chills, and sweats
- cold stage with shaking – 2. hot stage with high temperature (>104°F) – 3. sweating stage with resolution of fever
episodes last 6-10 hours, and then recur
every 2 days with P. vivax and P. ovale (tertian fever)
and for P. falciparum (malignant tertian fever)
every 3 days with P. malariae (quartan fever)
complicated/severe malaria
Can cause any of these:
• Cerebral malaria (change in mental status, coma)
• Respiratory distress
• Severe anemia (hct <15%)
• Renal failure
• Hypoglycemia
- Circulatory collapse (shock) and lactic acidosis
- Bleeding disorder (spontaneous bleeding or evidence of DIC)
******complications primarily occur with P falciparum, usually when parasitemia >2% (% of rbcs infected).
complicated malaria is usually with what species?
falciparum







